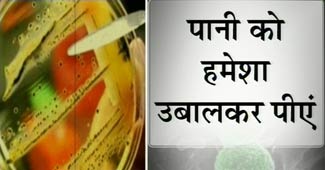
सुपरबग से बचने का उपाय

सुपरबग की पुष्टि ने बढ़ाई दिल्ली सरकार की मुश्किलें
सुपरबग की पुष्टि ने बढ़ाई दिल्ली सरकार की मुश्किलें
दिल्ली के मशहूर गंगाराम अस्पताल में मरीजों में सुपरबग होने की पुष्टि के बाद दिल्ली सरकार सकते हैं. हम बात कर रहे हैं उस बैक्टिरिया की, जिसे सुपरबग कहते हैं. वैसा सुपरबग जिसपर एंटी बायोटिक्स का भी इस्तेमाल नहीं होता है.